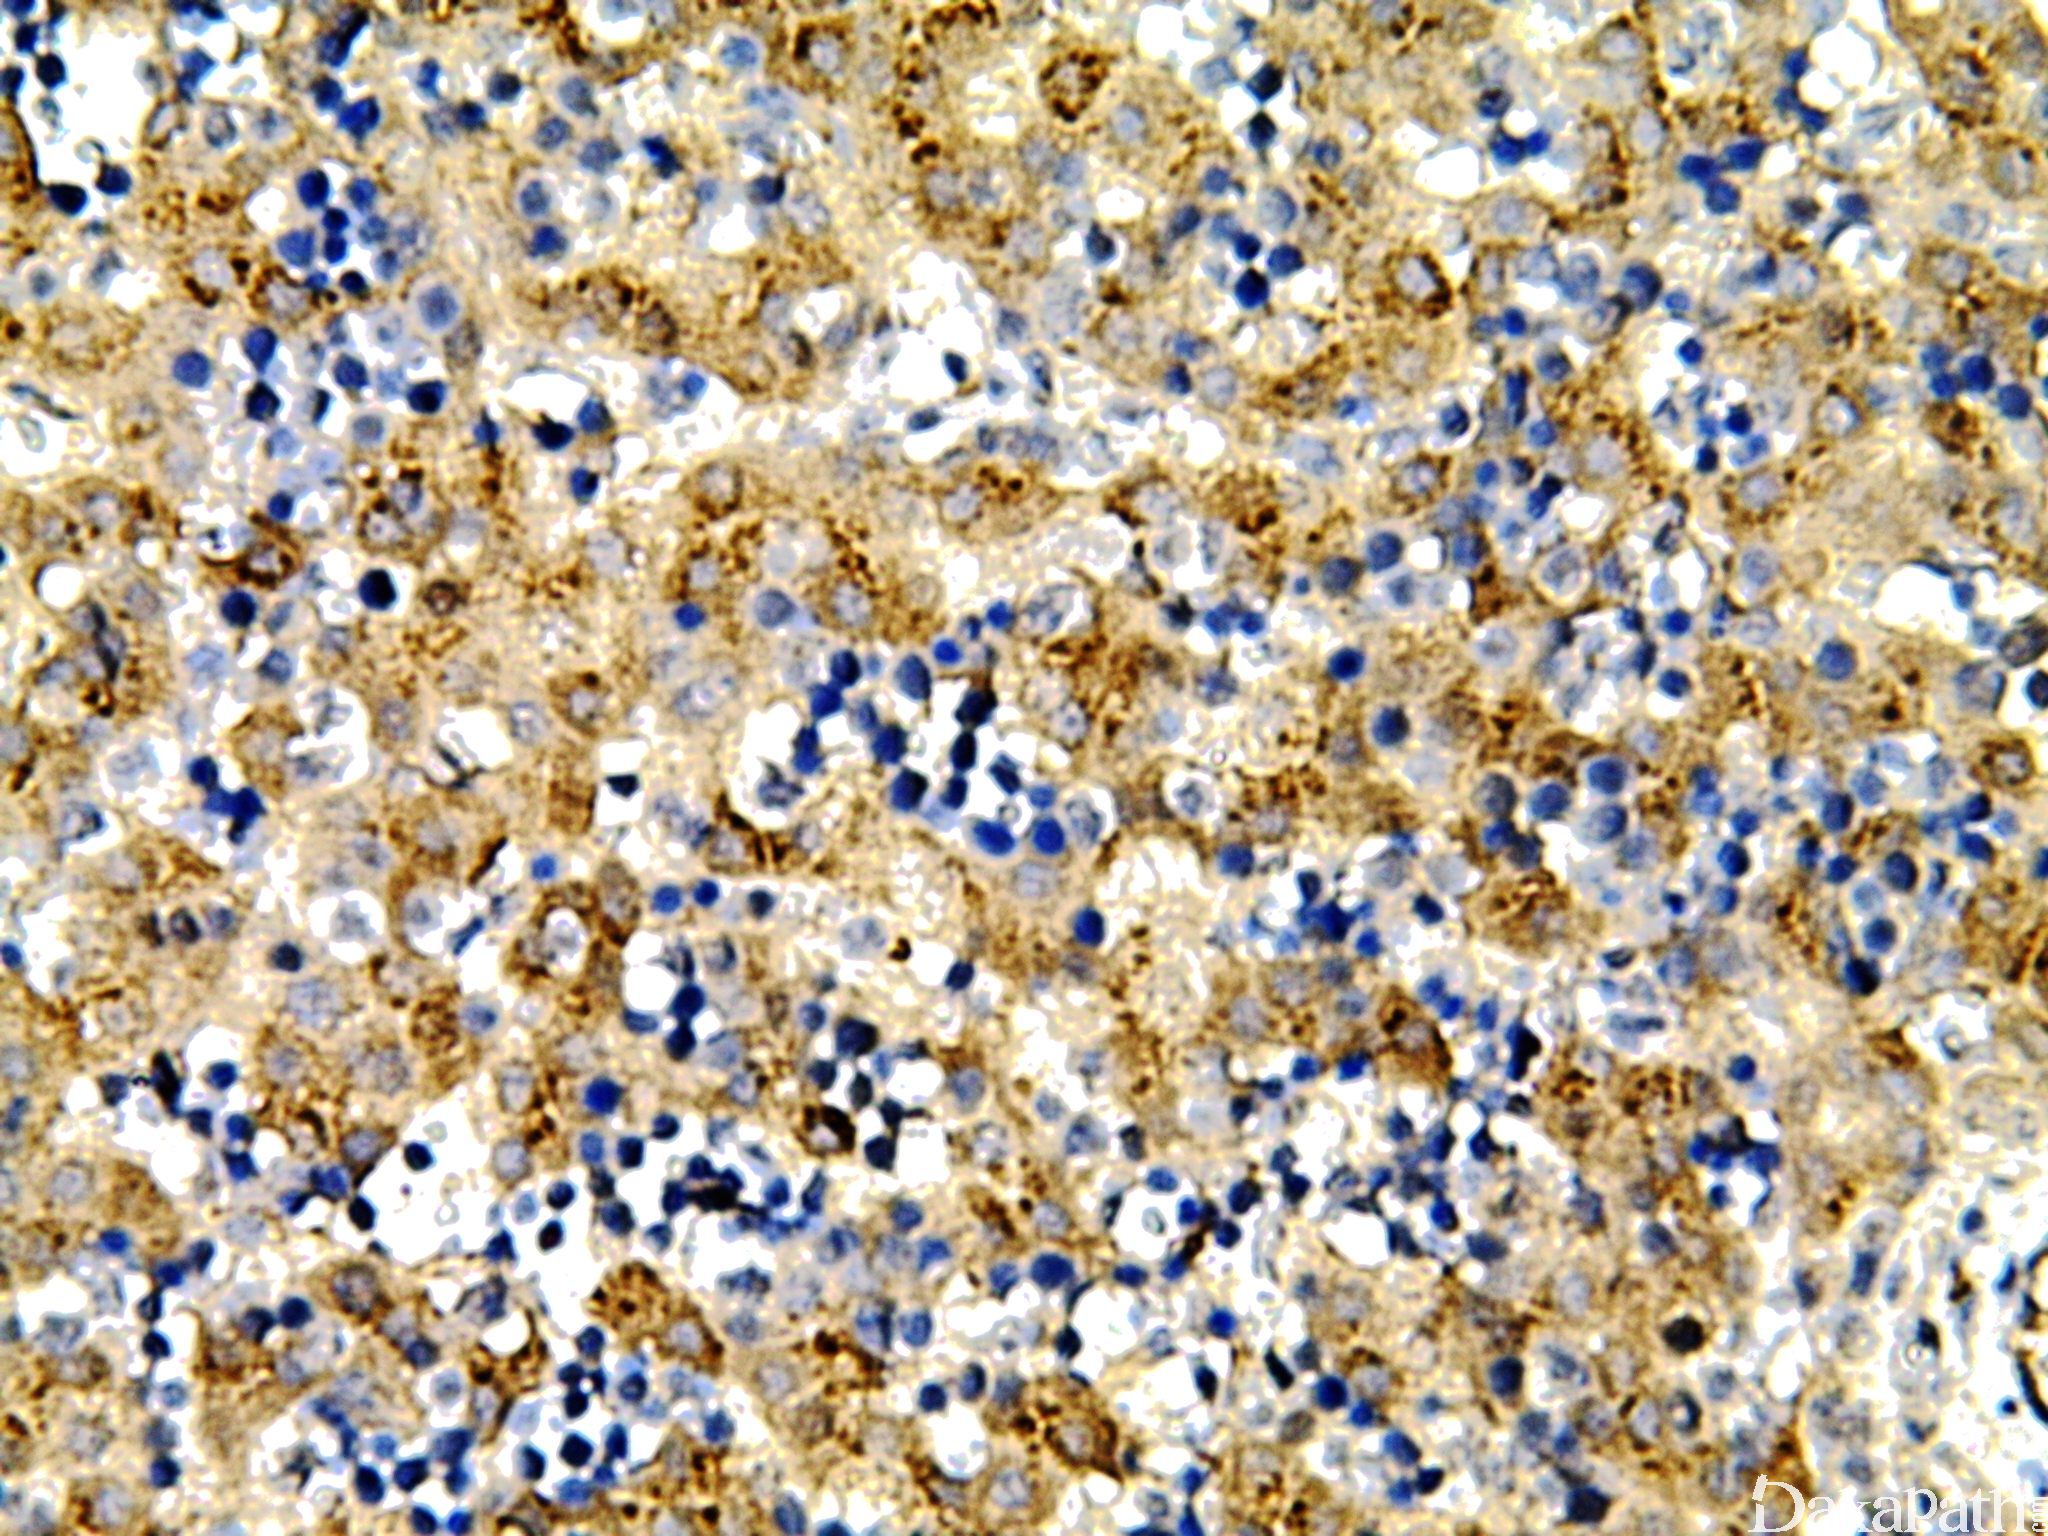

AFP

别名: 甲胎蛋白;α-fetoprotein、Alpha-Fetoprotein
概述:
是一种胚胎卵黄囊蛋白,由胚胎早期卵黄囊、胃肠道及肝脏产生。正常表达于胎儿肝脏和卵黄囊内胚层,可出现于多种生殖细胞肿瘤中,和卵巢、睾丸的卵黄囊瘤中。
信号定位: 胞浆
在病理学中的应用:
标记肝癌、内胚窦瘤、胚胎性癌。
肝细胞癌与胆管癌及转移性腺癌的鉴别诊断:在肝细胞癌中 AFP 特异性高,敏感性低;
睾丸及卵巢生殖细胞肿瘤的鉴别诊断;
肝样腺癌与其他腺癌的鉴别诊断。
商品化试剂(排名不分先后,本网站对抗体质量不负责!)
公司 | 克隆号 | 即用型(ml) | 原液(ml) | ||||
中杉金桥 | ZSA06 | 1.5 | 3 | 6 | / | 0.1 | 0.2 |
EP209 | |||||||
基因科技 | poly | 1 | 2 | 4 | 7 | / | 0.2 |
安必平 | / | 1.5 | 3 | 6 | / | 0.1 | 0.2 |
基因科技 | Poly | 1 | 2 | 4 | 7 | / | 0.2 |
